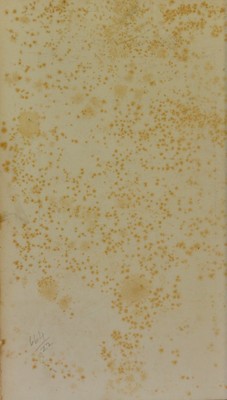

Traité pratique du microscope, et de son emploi dans l'étude des corps organisés / par L. Mandl ; suivi de Recherches sur l'organisation des animaux infusoirs par C.-G. Ehrenberg.
- Lajos Lázár Mandl
- Date:
- 1839
Licence: Public Domain Mark
Credit: Traité pratique du microscope, et de son emploi dans l'étude des corps organisés / par L. Mandl ; suivi de Recherches sur l'organisation des animaux infusoirs par C.-G. Ehrenberg. Source: Wellcome Collection.
Provider: This material has been provided by The University of Glasgow Library. The original may be consulted at The University of Glasgow Library.
1/530